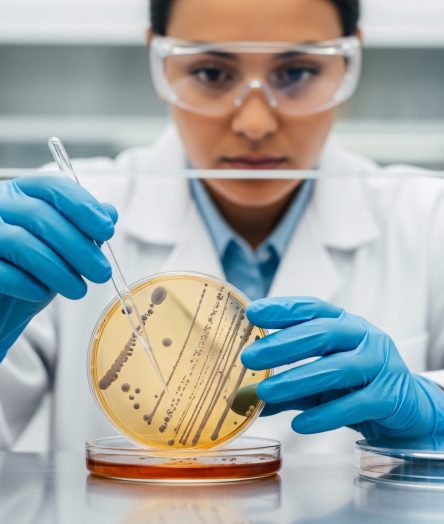

Destacamos
Está Pasando en UNAB
Comprometidos con la calidad
08 junio 2026
Por quinto año consecutivo UNAB se ubica entre las cinco mejores universidades del país en el Center for World University Rankings (CWUR)
La medición internacional evaluó a más de 21 mil instituciones de educación superior y posicionó a la Universidad Andrés Bello entre las cinco mejores del país y en el lugar 38 de Latinoamérica y el Caribe, destacando su desempeño en investigación, calidad académica e impacto científico a nivel global.
Lo más leído



Lo más leído
Agenda UNAB


Política
Programa Incluencers, tercera temporada, capítulo 1: Claudio Castro, alcalde de Renca, y Felipe Alessandri, alcalde de Lo Barnechea
Día: 11 de junio 2026
Hora: 09:00 Hrs

Salud
I Jornada de Maternidades, Técnicas de Reproducción Humana Asistida (TRHA) y Justicia Reproductiva
Día: 17 de junio 2026
Hora: 08:30 Hrs
Estudia con nosotros
Carreras de Pregrado Diurno
Carreras de Pregrado Vespertino
Carreras Advance
International College
Carreras y Programas online
Programas de Magíster
Doctorados
Especialidades Médicas
Especialidades Odontológicas
Diplomados y Cursos